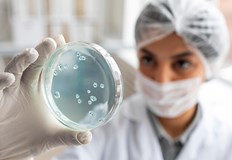
През последните 24 часа са поставени 87 ваксини 81 са новите

... София област - 0; София град - 4; Стара Загора - 0; Търговище - 1; Хасково - 0; Шумен - 0; Ямбол - 0 души.
Русе Коронавирус - Новини
TD 5 са новите случаи на коронавирус у нас Направени са
...... София област - 0; София град - 1; Стара Загора - 0; Търговище - 0; Хасково - 0; Шумен - 0; Ямбол - 0 души.
TD 98 са новите случаи на COVID 19 в България Направени са
...... София област - 2; София град - 22; Стара Загора - 3; Търговище - 0; Хасково - 4; Шумен - 1; Ямбол - 3 души.
TD 62 са новите случаи на коронавирус у нас Направени са
...... София област - 5; София град - 24; Стара Загора - 0; Търговище - 1; Хасково - 1; Шумен - 1; Ямбол - 1 души.
TD 269 са новите случаи на коронавирус у нас Направени са 2
...... София област - 11; София град - 84; Стара Загора - 6; Търговище - 0; Хасково - 7; Шумен - 3; Ямбол - 8 души.
TD 214 са новите случаи на коронавирус у нас Направени са
...... София област - 10; София град - 69; Стара Загора - 6; Търговище - 1; Хасково - 6; Шумен - 0; Ямбол - 5 души.
TD 288 са новите случаи на коронавирус у нас Направени са 2471
...... София област - 11; София град - 103; Стара Загора - 6; Търговище - 1; Хасково - 2; Шумен - 6; Ямбол - 7 души.
TD 262 са новите случаи на коронавирус у нас Направени са
...... София област - 10; София град - 81; Стара Загора - 11; Търговище - 1; Хасково - 9; Шумен - 5; Ямбол - 9 души.
TD 191 са новите случаи на коронавирус у нас Направени са 2129
...... София област - 6; София град - 58; Стара Загора - 4; Търговище - 4; Хасково - 10; Шумен - 1; Ямбол - 7 души.
TD 269 са новите случаи на коронавирус у нас Направени са 3
...... София област - 11; София град - 78; Стара Загора - 2; Търговище - 6; Хасково - 5; Шумен - 4; Ямбол - 6 души.
TD 296 са новите случаи на коронавирус у нас Направени са
...... София област - 18; София град - 61; Стара Загора - 20; Търговище - 4; Хасково - 6; Шумен - 5; Ямбол - 2 души.
За последното денонощие няма починали няма поставени ваксини но няма
...... 0; София - 0; София град - 4; Стара Загора - 0; Търговище - 0; Хасково - 1; Шумен - 0; Ямбол - 1 човек.
Няма починали Двадесет и седем души са излекувани В болници за
...... 0; София - 0; София (столица) - 24; Стара Загора - 8; Търговище - 1; Хасково - 6; Шумен - 0; Ямбол - 1 човек.
Няма починали с потвърдена коронавирусна инфекцияВ Русенско само двама души
...... интензивно отделение.Излекувани през последното денонощие са четирима души. Активните случаи към момента са 2908. През последните 24 часа са поставени 3 дози ваксина срещу коронавирус.
Положителни са 3 6 от пробите в странатаВ Русенско новите случаи
...... в лечебни заведения са 27.За последния ден са поставени 107 дози ваксини срещу коронавирус, а общо от началото на ваксинационната кампания - 4 609 997.
149 са новите случаи на коронавирус у насНаправени са 3289
...... София област - 3; София град - 48; Стара Загора - 2; Търговище - 2; Хасково - 0; Шумен - 2; Ямбол - 0 души.
Делът на положителните резултати в страната е 4 97 процентаВ Русенско
...... 249 души с диагноза COVID-19, от които 26 са в интензивно отделение. Излекуван през последното денонощие е един човек.Активните случаи към момента са 2 728.
Делът на положителните резултати в страната е 4 28 процентаВ Русенско
...... от които 26 са в интензивно отделение. Новопостъпилите в болница са 27. Излекувани през последното денонощие са 423 души. Активните случаи към момента са 2697.
115 са новите случаи на коронавирус у насНаправени са 3096
...... София област - 6; София град - 34; Стара Загора - 1; Търговище - 0; Хасково - 1; Шумен - 1; Ямбол - 5 души.
Делът на положителните резултати в страната е 4 6 процентаВ Русенско
...... към момента са 2957.През последните 24 часа са поставени пет дозиваксина срещу коронавирус, а общо от началото на ваксинационната кампания - 4 608 926 дози.
Делът на положителните резултати в страната е 3 9 процентаВ Русенско
...... загубили битката с новия коронавирус от потвърдените 1 297 006 заразени от началото на пандемията.От началото на ваксинационната кампания са поставени 4 608 921 дози.
26 са новите случаи на коронавирус у насНаправени са 647
...... София област - 0; София град - 6; Стара Загора - 0; Търговище - 1; Хасково - 0; Шумен - 0; Ямбол - 0 души.
Делът на положителните резултати за страната е 3 5 процентаНовите потвърдени
...... денонощие са трима души, а общо от началото на пандемията - 1 255 497.Общо от началото на ваксинационната кампания са поставени 4 608 622 дози.
Направени са 2 596 теста в цялата странаВ Русенско новите
...... лечебни заведения са 19.За последния ден са поставени 82 дози ваксина срещу коронавируса, а общо от началото на ваксинационната кампания - 4 608 615 дози.
През последните 24 часа са поставени 87 ваксини 81 са новите
...... София област - 3; София град - 27; Стара Загора - 4; Търговище - 0; Хасково - 0; Шумен - 3; Ямбол - 2 души.
Направени са 819 теста в странатаВ Русенско има само един
...... София област - 1; София град - 12; Стара Загора - 0; Търговище - 0; Хасково - 0; Шумен - 0; Ямбол - 0 души.
48 са новите случаи на коронавирус у насНаправени са 2806
...... София област - 2; София град - 15; Стара Загора - 3; Търговище - 0; Хасково - 1; Шумен - 3; Ямбол - 0 души.
През последното денонощие няма починали заразениВ Русенско новозаразените с коронавирус
...... общо от началото на ваксинационната кампания - 4 607 795 дози.Общо 38 194 души у нас са загубили битката с болестта от началото на пандемията.
Положителни са 1 7 от направените проби47 са новите случаи на
...... София област - 3; София град - 16; Стара Загора - 1; Търговище - 0; Хасково - 1; Шумен - 1; Ямбол - 0 души.
Поставени са 9 дози ваксина в странатаВ Русенско новозаразените с
...... заведение са 2.През последните 24 часа са поставени 9 дози ваксина срещу коронавируса, а общо от началото на ваксинационната кампания са поставени 4 607 299.
За последния ден са поставени 111 дози ваксини у насВ
...... в лечебни заведения са 9.За последния ден са поставени 111 дози ваксини срещу коронавирус, а общо от началото на ваксинационната кампания - 4 607 290.
91 са новите случаи за изминалото денонощие у нас91 са
...... 2 075 472-ма са със завършен имунизационен цикъл. 942 357 българи са с бустерна доза, а 69 788 души вече са си сложили адаптирана ваксина.
Делът на положителните проби в страната е едва 1 49 процентаВ
...... означава, че делът на положителните проби е 1,49 процента. Няма починали.През последното денонощие са хоспитализирани трима души с COVID-19. Няма новоприети пациенти в интензивни отделения.
Само 2 33 процента от преботие в страната са положителниТри са
...... 274 от тях са с поставена бустерна (подсилваща) доза, т. е. са реваксинирани, като на 69 705 човека е поставена бустерна доза с адаптирана ваксина.
Ковид си отива но грипът продължава да атакува53 са новите
...... София област - 0; София град - 15; Стара Загора - 0; Търговище - 0; Хасково - 0; Шумен - 2; Ямбол - 2 души.
През последното денонощие няма починали заразени с вирусаВ Русенско има
...... - 4 606 127. Общо 38 160 души у нас са загубили битката с коронавируса от потвърдените 1 294 848 заразени от началото на пандемията.
Делът на положителните резултати в страната е 3 9 процентаВ Русенско
...... кампания - 4 606 117.Общо 38 160 души у нас са загубили битката с коронавируса от потвърдените 1 294 818 заразени от началото на пандемията.
Първи случаи на коинфекция Първи случаи на коинфекция са доказани
...... се проточат, при възможност може да се преминава към онлайн обучение. В детските градини пък се провежда засилен филтър, за да не се допускат болни.
Направени са 3177 теста в цялата странаТрима са новозаразените с
...... в лечебни заведения са 33.За последния ден са поставени 220 дози ваксини срещу коронавирус, а общо от началото на ваксинационната кампания - 4 605 176.
Няма излекувани през последното денонощиеВ Русенско новите случаи на коронавирусната
...... с диагноза COVID-19, от които 40 са в интензивно отделение. Новопостъпилите в болница са 16.Няма излекувани през последното денонощие. Активните случаи към момента са 4048.
Делът на положителните резултати в страната е 9 07 процентаВ Русенско
...... поставени 4 603 029 дози.Общо 38 106 души у нас са загубили битката с коронавируса от потвърдените 1 292 033 заразени от началото на пандемията.
Направени са 839 теста в цялата странаВ Русенско има само
...... Новопостъпилите в лечебни заведения са 20.За последния ден са поставени 8 дозиваксини срещу коронавирус, а общо от началото на ваксинационната кампания - 4 602 635.
През изминалия ден са направени над 2 200 теста в
...... Новопостъпилите в лечебни заведения са 47.За последния ден са поставени 208 дозиваксини срещу коронавирус, а общо от началото на ваксинационната кампания - 4 602 627.
73 нови случая на Ковид 19 отчитат здравните власти в Русенско
...... Бустерна доза пък е направена на общо 27 840 русенци. Бустер с адаптирана ваксина е поставен на 1895 души, сочи справка в Единния информационен портал.
Няма починали през денонощиетоВ Русенска област новозаразените с коронавирус са
...... 24 часа са направени са 965 теста.Няма починали през денонощието.385 души с вируса се лекуват в болница. От тях 30 са настанени в интензивно отделение.
Починали са 4 пациенти с потвърдена коронавирусна инфекция през последното
...... в болница са 388 души с диагноза COVID-19, от които 31 са в интензивно отделение.През последните 24 часа са поставени 319 дози ваксина срещу COVID-19.
59 са новите случаи на коронавирус у нас за едно
...... София област - 4; София град - 15; Стара Загора - 3; Търговище - 1; Хасково - 0; Шумен - 0; Ямбол - 0 души.
Направени са 968 теста в странатаСамо 4 нови случаи на
...... лечебно заведение са 9.През последните 24 часа са поставени 6 дози ваксини срещу коронавируса, а общо от началото на ваксинационната кампания - 4 599 623.
Направени са 3086 теста в страната8 са новите случаи на
...... Новопостъпилите в лечебни заведения са 60.За последния ден са поставени 470 дозиваксини срещу коронавирус, а общо от началото на ваксинационната кампания - 4 599 617.